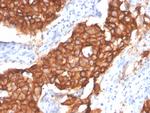
HER-2/c-erbB-2/neu/CD340 Antibody in Immunohistochemistry (Paraffin) (IHC (P))

Search
NeoBiotechnologies
HER-2/c-erbB-2/neu/CD340 Recombinant Rabbit Monoclonal Antibody (ERBB2/4439)
{{$productOrderCtrl.translations['antibody.pdp.commerceCard.promotion.promotions']}}
{{$productOrderCtrl.translations['antibody.pdp.commerceCard.promotion.viewpromo']}}
{{$productOrderCtrl.translations['antibody.pdp.commerceCard.promotion.promocode']}}: {{promo.promoCode}} {{promo.promoTitle}} {{promo.promoDescription}}. {{$productOrderCtrl.translations['antibody.pdp.commerceCard.promotion.learnmore']}}
产品信息
2064-RBM39-P0
种属反应
宿主/亚型
Expression System
分类
类型
克隆号
抗原
偶联物
形式
浓度
纯化类型
保存液
内含物
保存条件
运输条件
靶标信息
ErbB2 (HER2) is a receptor tyrosine kinase that is overexpressed in some breast tumors. Herceptin, used in treatment of metastatic Her2-positive cancer, is monoclonal antibody targeting this kinase.
仅用于科研。不用于诊断过程。未经明确授权不得转售。
篇参考文献 (0)
生物信息学
蛋白别名: c-erb B2/neu protein; CD antigen CD340; CD340; erb-b2; erbb 2; ErbB2 (pTyr1139); ErbB2 (pY1139); ErbB2 phospho Y1139; her 2; herstatin; human epidermal growth factor receptor 2; metas; Metastatic lymph node gene 19 protein; MLN 19; neuro/glioblastoma derived oncogene homolog; neuroblastoma/glioblastoma derived oncogene homolog; p185erbB2; phospho ErbB2; Proto-oncogene c-ErbB-2; Proto-oncogene Neu; Receptor tyrosine-protein kinase erbB-2; Tyrosine kinase-type cell surface receptor HER2; v-erb-b2 avian erythroblastic leukemia viral oncogene homolog 2; v-erb-b2 avian erythroblastic leukemia viral oncoprotein 2; v-erb-b2 erythroblastic leukemia viral oncogene homolog 2, neuro/glioblastoma derived oncogene homolog
基因别名: CD340; ERBB2; HER-2; HER-2/neu; HER2; MLN 19; MLN19; NEU; NGL; TKR1
UniProt ID: (Human) P04626
Entrez Gene ID: (Human) 2064